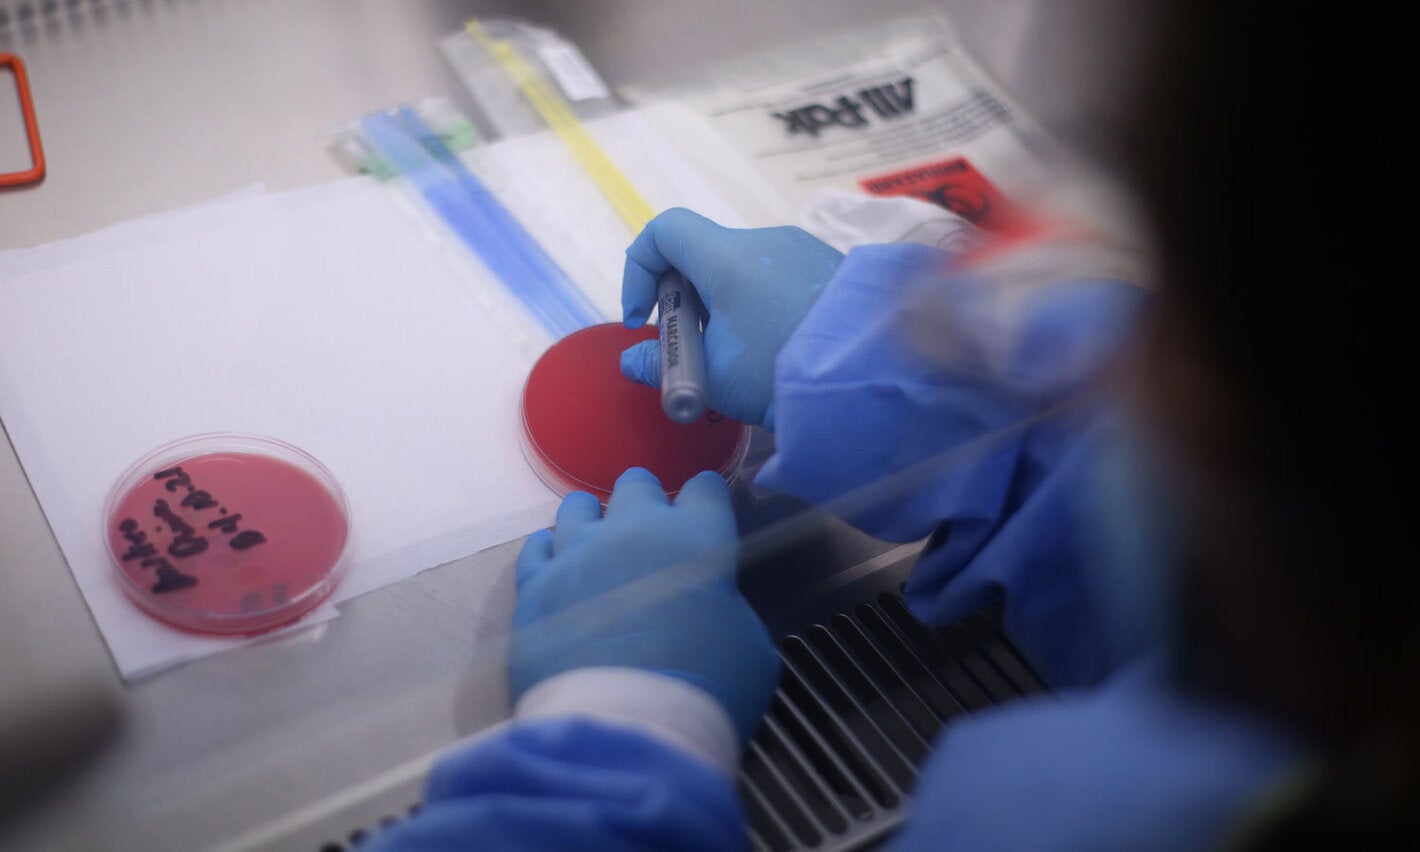

Honduras has celebrated 32 years since the last recorded case of poliomyelitis and that fact is as shocking as it is hopeful, since despite being a latent threat, it is possible to control it.
Dr. Roxana Elizabeth Castillo Rivera Works in the parasitology laboratory of the “Alonso Suazo” Health Center, the largest in the Honduran capital, where she is responsible for the surveillance the pneumococcal, meningococcal pneumonia, and rotavirus vaccines. 50 years ago, shortly before her first birthday, she contracted polio, a crippling disease. Since then, vaccines and knowledge about them have been reoccurring themes in her life.
“The girl who helped in the house was told that her little girl was unwell. The child had polio, but we didn’t know that. Her condition was very delicate, serious and she died soon after, but in those days, I lived with her, we shared toys and food. The transmission is fecal or oral, so there had to be some contact with the virus and it affected me. Above all my right side, the lower extremities”, related the doctor.
Roxana’s illness was a before and an after in her family. “When it was my turn to get the (polio) vaccine, they didn’t do it because I was sick, I had fever and back then it was handled that children with a fever were not vaccinated. From that moment, my father made us see the importance of vaccines, it became a very important issue for everyone, especially the importance of being able to have access to medications and prevention”, she stressed.
The doctor, with more than 20 years of laboratory experience, is today one of the most prominent vaccine specialists in Honduras and is aware of the paradox that this means in her life. “I was affected by a disease that is vaccine-preventable, and in my career and my work I had to work on the issues of vaccines. As I studied, I was able to relate to what I had experienced and compare it with scientific knowledge. How it affected the disease, what the vaccine was, then I was understanding what had caused me to be given this disability and it made me more aware of what a vaccine can prevent” she explains.